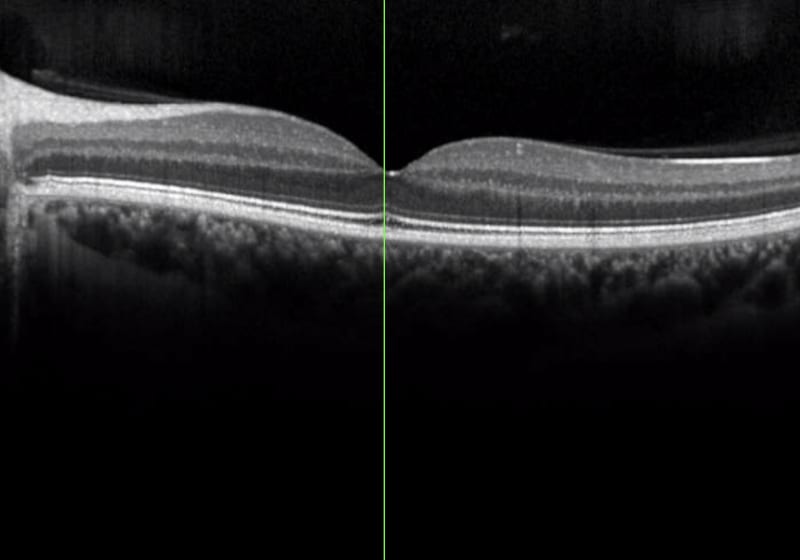

Konservative Augenheilkunde
Ihre Augen sind uns wichtig – egal, ob alltägliche Erkrankungen wie Lidentzündungen, Fremdkörperverletzungen und grauer Star, oder seltene Veränderungen wie Uveitis und Netzhautdystrophie. Deshalb nehmen wir uns ausreichend Zeit für Ihre Beschwerden. Wir nutzen hierzu unsere modernen Untersuchungsmethoden zur Diagnosestellung, erklären Ihnen im Anschluss alle in Frage kommenden Therapieoptionen und beraten Sie, sodass Sie sich für die beste Behandlung entscheiden können.